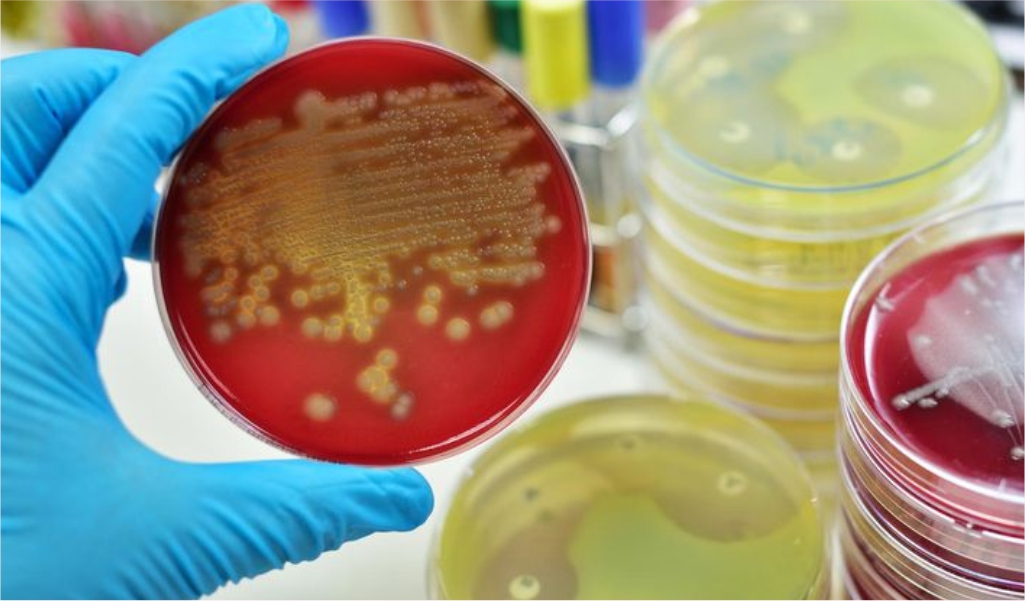
Почему тампоны могут привести к СТШ

Безопасны ли тампоны
Тампоны безопасны, но могут привести к смерти? О чем говорят новые исследования
Жизнь Лорен Вассер, модели и баскетболистки из Калифорнии, полностью изменилась, когда она открыла коробку с тампонами. Если бы Лорен знала, что будет дальше, она никогда не взяла бы ее в руки!

“Необходимо больше информации о том, что может произойти, если вы используете тампоны, - скажет Лорен через несколько лет, когда оправится от тяжелой депрессии и научится жить с протезами. - В рекламе тампонов вы видите девушку, бегущую по пляжу, но где предупреждение о потенциальном смертельном вреде, который может нанести этот продукт?”
Лорен пострадала от СТШ, синдрома токсического шока, потенциально смертельного состояния, которое может спровоцировать обычный тампон. Родители нашли девушку на полу с температурой около 42 градусов. У нее отказали почки, она пережила два сердечных приступа. Чтобы спасти Лорен жизнь, врачам пришлось ампутировать ей ногу, а через несколько лет и вторую.
СТШ - реакция организма на отравление токсинами, который выделяет золотистый стафилококк (а примерно 40% людей - бессимптомные носители этой бактерии). Считается, что синдром может развиться, если носить тампон больше шести часов, но Лорен использовала его правильно, по инструкции, указанной на упаковке.
Это один из самых известных обсуждаемых примеров СШТ, синдрома токсического шока. Сейчас Лорен снимает документальный фильм о своем страшном опыте.
Почему тампоны могут привести к СТШ?
В 90-х в европейских странах фиксировали примерно по 40 случаев СТШ в год. В России женщины в те годы как-то не доверяли тампонам, поэтому в нашей стране ситуация не была такой ужасной.
Сейчас о синдроме токсического шока как будто забыли, поэтому женщины мало осведомлены об этом потенциально смертельном состоянии. Корпорациям пришлось изменить материалы, из которых делают тампоны: вместо ужасной карбоксиметилцеллюлозы (ее применяют также в производстве моющих средств и клея) они теперь используют хлопок или целлюлозу. Но риск СТШ от этого не исчез.
Кровь внутри тампонов - идеальная среда для размножения бактерий, в том числе золотистого стафилококка. Он выделяет токсин, который атакует почки, печень и легкие. Начинается все с высокой температуры и сыпи, а если вовремя не оказать помощь, возможны кома и смерть.
-
Если не менять тампон дольше 6 часов, риск СТШ вырастает вдвое;
-
Если оставить его на ночь - втрое.
Парадоксальным образом главное преимущество современных тампонов - высокая впитываемость - стало их главной проблемой. Впитывается не только кровь, но и “хорошие” выделения, а это нарушает природный баланс вагинальной смазки, что тоже может привести к СТШ.
Мы привыкли доверять рекламе и думаем: раз тампоны широко рекламируются, они безопасны. К сожалению, это не так. Отсюда строгие рекомендации специалистов не оставлять тампоны на ночь, менять их каждые четыре часа, выбирать минимальную степень впитываемости. Ответственные гинекологи всегда советуют женщинам все-таки не тампоны, а выбирать прокладки: их можно спокойно оставлять на всю ночь, они не находятся внутри тела и не приводят к СТШ.
Могут ли тампоны вызвать другие опасные болезни?

В последнее время появились новые публикации об опасности тампонов, уже не связанной с СТШ. Несколько независимых лабораторий провели исследования химического состава тампонов 12 мировых брендов. Выяснились печальные факты: исследователи нашли в них цинк и железо, медь и свинец, мышьяк, хлор и ртуть. В некоторых тампонов нашли даже следы пестицидов!
Как все эти опасные вещества вообще оказались в тампонах известных, заботящихся о своей репутации производителей? Дело отчасти в технологиях производства, отчасти в материалах.
Хлопок обрабатывают пестицидами, когда он еще растет в поле. На этой стадии в него попадает и свинец - крупнейшие в мире заводы по производству этого металла расположены недалеко от хлопковых полей. Дальше, в процессе производства, сырье отбеливают хлоросодержащими веществами. Остальные элементы попадают вместе с красками, ароматизаторами и другими химическими добавками.
К синдрому токсического шока эти добавки не приводят. Но они могут привести к другим страшным болезням: бесплодию, раку, сердечно-сосудистым заболеваниями и нарушениям эндокринной системы.
Кстати, ароматизаторы и другие химические вещества производители добавляют и в прокладки. Прокладки все равно безопасней тампонов, но, пожалуйста, заботьтесь о себе и читайте упаковку и выбирайте продукцию, сделанную из натурального сырья. Так, прокладки Secrets Lan изготовлены без использования химических ароматизаторов и других вредных ингредиентов. В их составе только природные компоненты: целебные масла или настоящие экстракты лекарственных трав.
Может ли тампон провоцировать молочницу?
Многие женщины после использования тампонов жалуются на молочницу. Может, это совпадение? Давайте посмотрим.
Человеческий организм устроен так, что любой его внутренний орган, имеющий выход вовне, покрыт защитной слизистой оболочкой. Сложное сообщество бактерий, обитающее во влагалище, сдерживают рост патогенных микроорганизмов и не позволяют “плохим” бактериям проникать внутрь.
Тампоны впитывают в себя не только кровь, но и естественные выделения, в которых живут эти лактобактерии. Количество лактобактерий во влагалище сильно уменьшается, их уже недостаточно, чтобы противостоять патогенной микрофлоре и сдерживать рост грибов.
Еще один момент: мы часто вынимаем тампоны заполненными на какую-то часть. Сухая поверхность оставляет микротравмы на слизистой, а это тоже создает благоприятные условия для патогенов.
Во всем мире отношение надзорных органов в области здравоохранения такое: они безопасны, но с оговорками, если выполнять множество условий. На наш взгляд, это нельзя назвать безопасностью. Пожалуйста, будьте осторожны. Заботьтесь о себе и покупайте безопасные и качественные прокладки Secrets Lan на Wildberries и Ozon

Товары
- Комментарии









